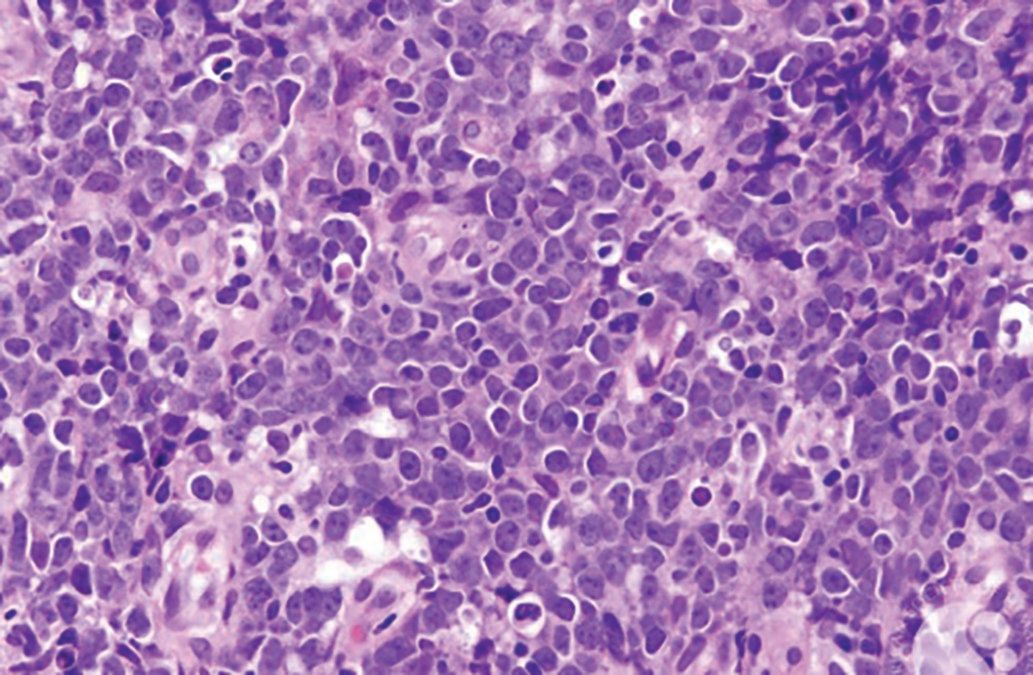

Test your diagnostic knowledge with this month's Image IQ.
Copur is a medical oncologist/ hematologist at Morrison Cancer Center, Mary Lanning Healthcare in Hastings, Nebraska, and is a professor at the University of Nebraska Medical Center in Omaha, Nebraska. He is also editor-at-Large and a Community Oncology Advisory Board member at ONCOLOGY.

Wedel is a staff pathologist at Mary Lanning Healthcare.

A woman, aged 76 years, presented with a bluish-purple lump in her mid- to upper medial left thigh. It started initially as a flat rash, and over a 2-month period, it turned into a mass measuring 2.5 cm by 3.1 cm (Figure 1). Work-up, including a PET-CT scan, showed the soft tissue mass on the inner thigh to have a Standardized Uptake Value of 4 (Figure 2); there were no other sites of disease. A biopsy of the lesion was performed (Figure 3).
A. Kaposi sarcoma
B. Malignant melanoma
C. Adult soft tissue sarcoma
D. Angiosarcoma
E. Lymphoma
E. Lymphoma
Primary cutaneous diffuse large B-cell lymphoma (LBCL), leg type, is a primary cutaneous LBCL of intermediate behavior. It represents 1% to 4% of all cutaneous lymphomas and approximately 10% to 20% of all primary cutaneous LBCLs.1,2 The disease predominantly affects elderly patients, with the male-to-female ratio ranging from 1:2 to 1:4. Typically, patients present with rapidly growing, solitary or clustered, red or bluish-red nodules or tumors located on 1 or both legs, which can ulcerate.3 These lymphomas are mostly limited to the skin at presentation. Histologically, observed is either a dense, diffuse infiltrate of a monotonous population; or confluent sheets of medium to large B cells with round nuclei, prominent nucleoli, and coarse chromatin resembling centroblasts and/or immunoblasts within the dermis and subcutis. The neoplastic B cells usually express B-cell markers (CD19, CD20, CD22, CD79a). Additionally, Bcl-2, MUM1/IRF4, IgM, and FOXP1 proteins are strongly positive.4 The frequent relapses require appropriate treatment decisions and a strict follow-up of the patients.
1. Sokol L, Naghashpour M, Glass LF. Primary cutaneous B-cell lymphomas: recent advances in diagnosis and management. Cancer Control. 2012;19(3):236-244. doi:10.1177/107327481201900308
2. Thomas V, Dobson R, Mennel R. Primary cutaneous large B-cell lymphoma, leg type. Proc (Bayl Univ Med Cent). 2011;24(4):350-353. doi:10.1080/08998289.2011.11928757
3. Kempf W, Denisjuk N, Kerl K, et al. Primary cutaneous B-cell lymphomas. J Dtsch Dermatol Ges. 2012;10(1):12-22; quiz 23. doi:10.1111/j.1610-0387.2011.07852.x
4. Hristov AC. Primary cutaneous diffuse large B-cell lymphoma, leg type: diagnostic considerations. Arch Pathol Lab Med. 2012;136(8):876–881. doi:10.5858/arpa.2012-0195-RA

Late Hepatic Recurrence From Granulosa Cell Tumor: A Case Report
Granulosa cell tumors exhibit late recurrence and rare hepatic metastasis, emphasizing the need for lifelong surveillance in affected patients.